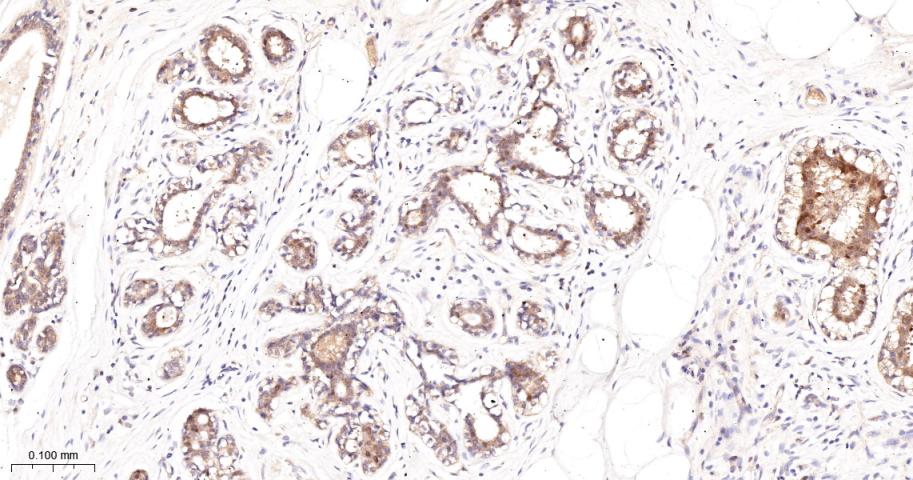
蛋白激酶C-δ/θ重组兔单抗

蛋白激酶C-δ/θ重组兔单抗
Rrmab?兔单抗

货号:bsm-62953R
产品详情
相关标记
相关产品
相关文献
常见问题
概述
产品编号
bsm-62953R
产品类型
重组兔单抗
英文名称
PKC delta/theta Recombinant Rabbit mAb
中文名称
蛋白激酶C-δ/θ重组兔单抗
英文别名
ALPS3; CVID9; MAY1; PKCD; nPKC-delta; D14Ertd420e; PKC[d]; PKCdelta; KPCD_HUMAN; PRKCD; Tyrosine-protein kinase PRKCD; 2.7.11.13; KPCD_MOUSE; KPCD_RAT;
抗体来源
Rabbit
免疫原
A synthesized peptide derived from human PKC delta: 100-350
亚型
IgG
性状
Liquid
纯化方法
affinity purified by Protein A
克隆类型
Recombinant
克隆号
15C18
理论分子量
78,82 kDa
检测分子量
78 kDa
储存液
10mM phosphate buffered saline(pH 7.4) with 150mM sodium chloride, 0.05% BSA, 0.02% Proclin300 and 50% glycerol.
研究领域
SWISS
Gene ID
保存条件
Store at 4℃ for short term. Store at -20℃ for long term. Avoid repeated freeze/thaw cycles.
注意事项
This product as supplied is intended for research use only, not for use in human, therapeutic or diagnostic applications.
数据库链接
背景资料
Calcium-independent, phospholipid- and diacylglycerol (DAG)-dependent serine/threonine-protein kinase that plays contrasting roles in cell death and cell survival by functioning as a pro-apoptotic protein during DNA damage-induced apoptosis, but acting as an anti-apoptotic protein during cytokine receptor-initiated cell death, is involved in tumor suppression as well as survival of several cancers, is required for oxygen radical production by NADPH oxidase and acts as positive or negative regulator in platelet functional responses.

产品应用
| 应用 | 已检合格种属 | 预测种属 | 推荐稀释比例 |
|---|---|---|---|
| WB | Human | Mouse, Rat | 1:1000-5000 |
| IHC-P | Human, Mouse, Rat | 1:100-500 | |
| IHC-F | Human, Mouse, Rat | 1:100-500 | |
| IF | Human, Mouse, Rat | 1:100-500 | |
| ICC/IF | Human, Mouse, Rat | 1:100-500 |
交叉反应
交叉反应: Human, Mouse, Rat
相关产品
暂无相关产品
靶标
基因名
PRKCD
蛋白名
Protein kinase C delta type
亚基
Interacts with PDK1 (via N-terminus region), RAD9A, CDCP1, MUC1 and VASP.
亚细胞定位
Cytoplasm. Cytoplasm, perinuclear region. Nucleus. Endoplasmic reticulum. Mitochondrion. Cell membrane; Peripheral membrane protein.
翻译后修饰
Autophosphorylated and/or phosphorylated at Thr-507, within the activation loop; phosphorylation at Thr-507 is not a prerequisite for enzymatic activity. Autophosphorylated at Ser-299, Ser-302 and Ser-304. Upon TNFSF10/TRAIL treatment, phosphorylated at Tyr-155; phosphorylation is required for its translocation to the endoplasmic reticulum and cleavage by caspase-3. Phosphorylated at Tyr-313, Tyr-334 and Tyr-567; phosphorylation of Tyr-313 and Tyr-567 following thrombin stimulation potentiates its kinase activity. Phosphorylated by protein kinase PDK1; phosphorylation is inhibited by the apoptotic C-terminus cleavage product of PKN2.
相似性
Belongs to the protein kinase superfamily. AGC Ser/Thr protein kinase family. PKC subfamily.
Contains 1 AGC-kinase C-terminal domain.
Contains 1 C2 domain.
Contains 2 phorbol-ester/DAG-type zinc fingers.
Contains 1 protein kinase domain.
Contains 1 AGC-kinase C-terminal domain.
Contains 1 C2 domain.
Contains 2 phorbol-ester/DAG-type zinc fingers.
Contains 1 protein kinase domain.
功能
Calcium-independent, phospholipid- and diacylglycerol (DAG)-dependent serine/threonine-protein kinase that plays contrasting roles in cell death and cell survival by functioning as a pro-apoptotic protein during DNA damage-induced apoptosis, but acting as an anti-apoptotic protein during cytokine receptor-initiated cell death, is involved in tumor suppression as well as survival of several cancers, is required for oxygen radical production by NADPH oxidase and acts as positive or negative regulator in platelet functional responses. Upon DNA damage, activates the promoter of the death-promoting transcription factor BCLAF1/Btf to trigger BCLAF1-mediated p53/TP53 gene transcription and apoptosis. In response to oxidative stress, interact with and activate CHUK/IKKA in the nucleus, causing the phosphorylation of p53/TP53. In the case of ER stress or DNA damage-induced apoptosis, can form a complex with the tyrosine-protein kinase ABL1 which trigger apoptosis independently of p53/TP53. In cytosol can trigger apoptosis by activating MAPK11 or MAPK14, inhibiting AKT1 and decreasing the level of X-linked inhibitor of apoptosis protein (XIAP), whereas in nucleus induces apoptosis via the activation of MAPK8 or MAPK9. Upon ionizing radiation treatment, is required for the activation of the apoptosis regulators BAX and BAK, which trigger the mitochondrial cell death pathway. Can phosphorylate MCL1 and target it for degradation which is sufficient to trigger for BAX activation and apoptosis. Is required for the control of cell cycle progression both at G1/S and G2/M phases. Mediates phorbol 12-myristate 13-acetate (PMA)-induced inhibition of cell cycle progression at G1/S phase by up-regulating the CDK inhibitor CDKN1A/p21 and inhibiting the cyclin CCNA2 promoter activity. In response to UV irradiation can phosphorylate CDK1, which is important for the G2/M DNA damage checkpoint activation. Can protect glioma cells from the apoptosis induced by TNFSF10/TRAIL, probably by inducing increased phosphorylation and subsequent activation of AKT1. Is highly expressed in a number of cancer cells and promotes cell survival and resistance against chemotherapeutic drugs by inducing cyclin D1 (CCND1) and hyperphosphorylation of RB1, and via several pro-survival pathways, including NF-kappa-B, AKT1 and MAPK1/3 (ERK1/2). Can also act as tumor suppressor upon mitogenic stimulation with PMA or TPA. In N-formyl-methionyl-leucyl-phenylalanine (fMLP)-treated cells, is required for NCF1 (p47-phox) phosphorylation and activation of NADPH oxidase activity, and regulates TNF-elicited superoxide anion production in neutrophils, by direct phosphorylation and activation of NCF1 or indirectly through MAPK1/3 (ERK1/2) signaling pathways. May also play a role in the regulation of NADPH oxidase activity in eosinophil after stimulation with IL5, leukotriene B4 or PMA. In collagen-induced platelet aggregation, acts a negative regulator of filopodia formation and actin polymerization by interacting with and negatively regulating VASP phosphorylation. Downstream of PAR1, PAR4 and CD36/GP4 receptors, regulates differentially platelet dense granule secretion; acts as a positive regulator in PAR-mediated granule secretion, whereas it negatively regulates CD36/GP4-mediated granule release. Phosphorylates MUC1 in the C-terminal and regulates the interaction between MUC1 and beta-catenin.
标记抗体
暂无标记数据
同靶标产品
暂无同靶标产品
相关文献
提示: 发表研究结果有使用 bsm-62953R 时请让我们知道,以便我们可以引用参考文章。作为回馈,资料提供者将获得我们送上的小礼品。
暂无相关文献
常见问题
暂无常见问题